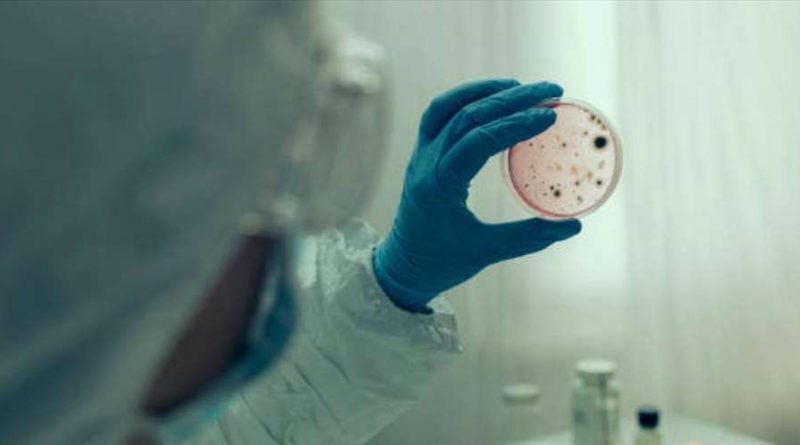

Συρία: Το Παρατηρητήριο Ανθρωπίνων Δικαιωμάτων κατηγορεί την Τουρκία για τη χολέρα στη Συρία
Κατηγορήθηκε σήμερα, Δευτέρα 7 Νοεμβρίου, η Τουρκία από το Παρατηρητήριο Ανθρωπίνων Δικαιωμάτων (HRW) για συμβολή στην εξάπλωση της χολέρας στη βόρεια Συρία, μέσω της μείωσης της ροής νερού από τον Ευφράτη, και το συριακό καθεστώς ότι παρεμποδίζει την παροχή βοήθειας σε περιοχές που τελούν υπό κουρδικό έλεγχο.
Συγκεκριμένα, για πρώτη φορά μετά από το 2009, η χολέρα επανεμφανίστηκε στις αρχές Σεπτεμβρίου στη Συρία, όπου περίπου τα δύο τρίτα των εργοστασίων επεξεργασίας υδάτων, τα μισά αντλιοστάσια και το ένα τρίτο των υδραγωγίων έχουν υποστεί ζημιές από έντεκα χρόνια πολέμου, σύμφωνα με τον ΟΗΕ.
Ο Άνταμ Κούγκλε, αναπληρωτής διευθυντής της HRW, αρμόδιος για τη Μέση Ανατολή και τη Βόρεια Αφρική, επισήμανε: «Αυτή η καταστροφική επιδημία χολέρας δεν θα είναι η τελευταία υδατογενής ασθένεια που θα επηρεάσει τους Σύρους, εκτός αν αντιμετωπιστούν άμεσα τα σοβαρά προβλήματα ύδρευσης της χώρας, ιδίως στό βορειοανατολικό τμήμα της χώρας».
Επιπλέον πρόσθεσε: «Η Τουρκία μπορεί και οφείλει να σταματήσει αμέσως να επιδεινώνει την κρίση του νερού στη Συρία».
Ακόμη, η ΜΚΟ διευκρινίζει ότι «οι τουρκικές αρχές δεν έχουν εξασφαλίσει επαρκή ροή νερού στο συριακό τμήμα του Ευφράτη και συνεχή προμήθεια νερού από το αντλιοστάσιο του Αλλούκ», το οποίο κατέχει η Τουρκία στη βόρεια Συρία.
«Η Τουρκία θα πρέπει να διασφαλίσει ότι μοιράζονται δίκαια οι υδάτινοι πόροι του Ευφράτη με τη Συρία και το Ιράκ και ότι ο σταθμός Αλλούκ θα ξαναρχίσει αμέσως την παροχή νερού σε κοινότητες που έχουν ανάγκη», πρόσθεσε.
Παράλληλα, ο Παγκόσμιος Οργανισμός Υγείας έχει αναφέρει 81 θανάτους και περισσότερα από 24.000 ύποπτα κρούσματα από το ξέσπασμα της επιδημίας στη Συρία, καταγράφοντας θύματα σε περιοχές που ελέγχονται από το καθεστώς, από τους αντάρτες και εκείνες που βρίσκονται υπό κουρδική διοίκηση.
Η ασθένεια ευνοείται από την απουσία αποχετευτικών συστημάτων ή πόσιμου νερού. Οι Κούρδοι της Συρίας κατηγορούν τη γειτονική Τουρκία, την οποία διασχίζει ο Ευφράτης, ότι κατακρατεί περισσότερο νερό από όσο χρειάζεται στα φράγματά της, μειώνοντας τη ροή του ποταμού στη συριακή πλευρά, κάτι που η Άγκυρα αρνείται.
Στη Συρία, περισσότεροι από πέντε εκατομμύρια άνθρωποι εξαρτώνται από τον Ευφράτη για πόσιμο νερό σύμφωνα με τον ΟΗΕ.
Το HRW κατηγόρησε επίσης, το συριακό καθεστώς ότι παρεμπόδισε την άφιξη βοήθειας που προορίζεται για την καταπολέμηση της χολέρας σε περιοχές που ελέγχονται από την κουρδική διοίκηση.
Τέλος, η ΜΚΟ κάλεσε «όλες τις πλευρές της σύγκρουσης» να παραχωρήσουν «ανεμπόδιστη πρόσβαση στα μέλη ανθρωπιστικών οργανισμών» σε όλες τις περιοχές της Συρίας.